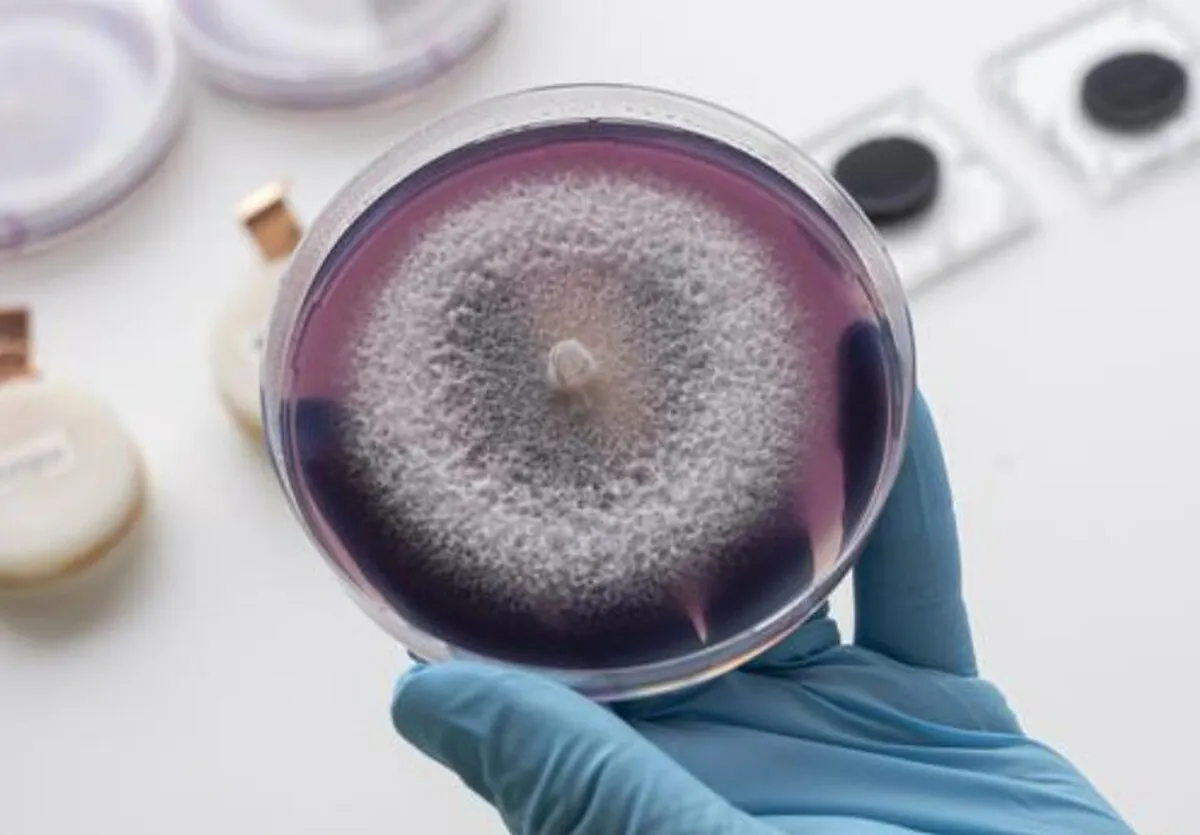

تولید برق از نان: ابداع باتری که پس از مصرف خود را هضم میکند
به گزارش خبرگزاری آنا به نقل ازIE، دانش پژوهان آزمایشگاه فدرال علوم و فناوری مواد سوئیس (EMPA) میگویند این باتریهای قارچی منبع انرژی کاملا زیست تخریب پذیر و غیر سمی هستند که میتواند انرژی حسگرهای دما و سایر دستگاههای کوچک مشابه را تامین کنند.
پیش از این دانشمندان با استفاده از باکتری ها، باتریهای زنده ساخته بودند. با این حال، احتمالاً این نخستین بار است که محققان پیل سوختی میسازند که از قدرت دو قارچ مختلف استفاده میکند: «Saccharomyces cerevisiae» (مخمر نان) و «Trametes pubescens» (قارچ پوسیده سفید).
قارچ اول معمولاً برای تهیه نان و پنیر استفاده میشود، در حالی که دومی به دلیل توانایی اش در تصفیه فاضلاب و کاهش سمیت فلزات سنگین در محصولات معروف است.
این پژوهش حاکی از آن است این دو قارچ در ترکیب با نانو کریستالهای سلولز و نانوفیبریلهای سلولز میتوانند به صورت سه بعدی چاپ شده و در جوهرهای مبتنی بر سلولز رشد میکنند. محققان میگویند افزودن تکههای کربن سیاه و گرافیت به جوهرها باعث میشود آنها به صورت الکترونیکی برای استفاده بالقوه به عنوان الکترود در باتریهای قارچی، به ویژه پیلهای سوختی میکروبی (MFC)، رسانا شوند.
همه موجودات زنده، از جمله قارچ ها، مواد مغذی آلی را از غذای خود برای تولید انرژی میسوزانند. این پیل سوختی قارچی جدید نیز از مکانیزم مشابهی برای تبدیل بخشی از این انرژی به برق بهره میبرد.
مجریان این طرح ابتدا با استفاده از سلولز و سلولهای قارچی نوعی جوهر تهیه کردند. آنها به طور خاص از سلولز استفاده کردند چرا که تداخلی در رشد طبیعی قارچها ایجاد نمیکند. سپس از این جوهر برای چاپ سه بعدی اجزای باتری استفاده کردند.
مانند هر باتری دیگری، پیل سوختی قارچی نیز از یک آند و یک کاتد تشکیل شده است. سمت آند مخمر نان را در خود جای داده است که از طریق متابولیسم خود، الکترون آزاد میکند. از طرف دیگر، کاتد است که توسط قارچ پوسیدگی سفید اشغال شده و آنزیمی تولید میکند که جذب و انتقال این الکترونها به خارج از سلول را امکان پذیر میکند.
قطعا این باتری قارچی نمیتواند انرژی مورد نیاز دستگاههای بزرگ را تامین کند، اما در آزمایش ها، با موفقیت ولتاژ بین ۱۰۰ تا ۲۰۰ میلی ولت را تولید کرد که این برای روشن کردن حسگرهای بلوتوثی کوچک که بر تغییرات دما نظارت میکنند کافی است.
«کارولینا ریس» «Carolina Reyes» مجری این تحقیقات گفت: «می توانید باتریهای قارچی را در حالت خشک، ذخیره و با افزودن آب و مواد مغذی آنها را در محل مورد فعال کنید».
در حالی که جمع آوری و بازیافت دستگاههای الکترونیکی بزرگ آسان است، حسگرها و سایر قطعات الکترونیکی کوچک اغلب مورد توجه قرار نمیگیرند. این اجزا که معمولاً از مواد غیرقابل تجزیه زیستی ساخته میشوند اغلب حاوی مواد سمی هستند که در نهایت خاک و آب را آلوده میکنند.
بر اساس تخمینهای پژوهشگران سوئیسی، تا سال ۲۰۳۰، دور ریخته شدن وسایل الکترونیکی دارای قطعاتی که به راحتی قابل بازیافت و تجریه نیستند، موجب جمع شدن ۷۴.۷ میلیون تن زباله الکترونیکی میشود و این یعنی تا سال ۲۰۳۰، باید با زبالههای الکترونیکی غیرقابل بازیافت با وزنی معادل ۱۰ هزار برج ایفل مقابله کنیم. تصور کنید که ما و محیط زیستمان به دلیل چنین مقادیر زیادی زبالههای سمی الکترونیکی با چه مشکلاتی روبهرو خواهد شد.
مجریان این پژوهش تاکید دارند: «بنابراین، نیاز سریع به توسعه الکترونیک سبز وجود دارد که از مواد سازگار با محیط زیست، غیرسمی و تجدیدپذیرتر در اجزای خود استفاده میکند.»
هدف بعدی محققان EMPA افزایش عمر و توان خروجی این باتری قارچی است تا بتوان از آن برای قطعات الکترونیکی بزرگتر استفاده کرد.
نتایج این تحقیقات درنشریه ACS Sustainable Chemistry & Engineering منتشر شده است.
انتهای پیام/
- هدایای تبلیغاتی
- غذای شرکتی
- تور استانبول
- غذای سازمانی
- خرید کارت پستال
- لوازم یدکی تویوتا قطعات تویوتا
- مشاوره حقوقی
- تبلیغات در گوگل
- بهترین کارگزاری بورس
- ثبت نام آمارکتس
- سایت رسمی خرید فالوور اینستاگرام همراه با تحویل سریع
- یخچال فریزر اسنوا
- گاوصندوق خانگی
- تاریخچه پلاک بیمه دات کام
- ملودی 98
- خرید سرور اختصاصی ایران
- بلیط قطار مشهد
- رزرو بلیط هواپیما
- ال بانک
- آهنگ جدید
- بهترین جراح بینی ترمیمی در تهران
- اهنگ جدید
- خرید قهوه
- اخبار بورس
























